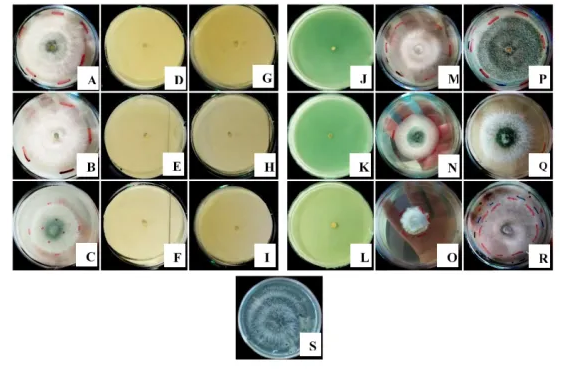
image.png

長期使用化學投入品提高土壤肥力和控制病害,雖然在一定程度上滿足了全球糧食需求,但也帶來了不可預見的環境問題,如土壤中細菌和真菌拮抗種群的減少以及土傳病害的增加。盡管對環境有各種有害影響,但全球殺菌劑和肥料的使用量持續上升,但其對環境的負面影響促使人們尋找更可持續的農業管理方法。微生物接種劑(如木霉菌)作為一種生物防治劑,顯示出替代化學品的潛力。木霉菌是一種廣泛存在于土壤中的無性繁殖真菌,能夠對抗多種土傳病原體,并通過誘導植物的局部和系統性抗性來增強植物的免疫力、生長和發育。自20世紀20年代以來,木霉菌已被用于土壤病害的防治,特別是哈茨木霉、綠色木霉等菌株,因其多樣的作用機制(如菌寄生、抗生素分泌等)而被認為是有前景的生物防治劑。研究表明,木霉菌不僅能有效抑制多種植物病原菌的生長,還能改善土壤結構和養分狀況。各種Trichoderma harzianum菌株單獨使用或與殺菌劑組合使用,在綜合病害管理中對各種種傳和土傳病害的管理中發揮著關鍵作用。然而,幾種化學物質會損害木霉菌的生長。因此,為了長遠發展,采用環境友好的方法進行病害管理,阻止病原體對化學品產生抗性,該研究評估了哈茨木霉菌與化學殺菌劑在控制植物病原體方面的兼容性,并為選擇不損害哈茨木霉菌生長和有效性的殺菌劑提供了見解,從而能夠制定出增強病害抑制效果同時減少化學投入的綜合策略。

長期使用化學投入品提高土壤肥力和控制病害,雖然在一定程度上滿足了全球糧食需求,但也帶來了不可預見的環境問題,如土壤中細菌和真菌拮抗種群的減少以及土傳病害的增加。盡管對環境有各種有害影響,但全球殺菌劑和肥料的使用量持續上升,但其對環境的負面影響促使人們尋找更可持續的農業管理方法。微生物接種劑(如木霉菌)作為一種生物防治劑,顯示出替代化學品的潛力。木霉菌是一種廣泛存在于土壤中的無性繁殖真菌,能夠對抗多種土傳病原體,并通過誘導植物的局部和系統性抗性來增強植物的免疫力、生長和發育。自20世紀20年代以來,木霉菌已被用于土壤病害的防治,特別是哈茨木霉、綠色木霉等菌株,因其多樣的作用機制(如菌寄生、抗生素分泌等)而被認為是有前景的生物防治劑。研究表明,木霉菌不僅能有效抑制多種植物病原菌的生長,還能改善土壤結構和養分狀況。各種Trichoderma harzianum菌株單獨使用或與殺菌劑組合使用,在綜合病害管理中對各種種傳和土傳病害的管理中發揮著關鍵作用。然而,幾種化學物質會損害木霉菌的生長。因此,為了長遠發展,采用環境友好的方法進行病害管理,阻止病原體對化學品產生抗性,該研究評估了哈茨木霉菌與化學殺菌劑在控制植物病原體方面的兼容性,并為選擇不損害哈茨木霉菌生長和有效性的殺菌劑提供了見解,從而能夠制定出增強病害抑制效果同時減少化學投入的綜合策略。
長期使用化學投入品提高土壤肥力和控制病害,雖然在一定程度上滿足了全球糧食需求,但也帶來了不可預見的環境問題,如土壤中細菌和真菌拮抗種群的減少以及土傳病害的增加。盡管對環境有各種有害影響,但全球殺菌劑和肥料的使用量持續上升,但其對環境的負面影響促使人們尋找更可持續的農業管理方法。微生物接種劑(如木霉菌)作為一種生物防治劑,顯示出替代化學品的潛力。木霉菌是一種廣泛存在于土壤中的無性繁殖真菌,能夠對抗多種土傳病原體,并通過誘導植物的局部和系統性抗性來增強植物的免疫力、生長和發育。自20世紀20年代以來,木霉菌已被用于土壤病害的防治,特別是哈茨木霉、綠色木霉等菌株,因其多樣的作用機制(如菌寄生、抗生素分泌等)而被認為是有前景的生物防治劑。研究表明,木霉菌不僅能有效抑制多種植物病原菌的生長,還能改善土壤結構和養分狀況。各種Trichoderma harzianum菌株單獨使用或與殺菌劑組合使用,在綜合病害管理中對各種種傳和土傳病害的管理中發揮著關鍵作用。然而,幾種化學物質會損害木霉菌的生長。因此,為了長遠發展,采用環境友好的方法進行病害管理,阻止病原體對化學品產生抗性,該研究評估了哈茨木霉菌與化學殺菌劑在控制植物病原體方面的兼容性,并為選擇不損害哈茨木霉菌生長和有效性的殺菌劑提供了見解,從而能夠制定出增強病害抑制效果同時減少化學投入的綜合策略。